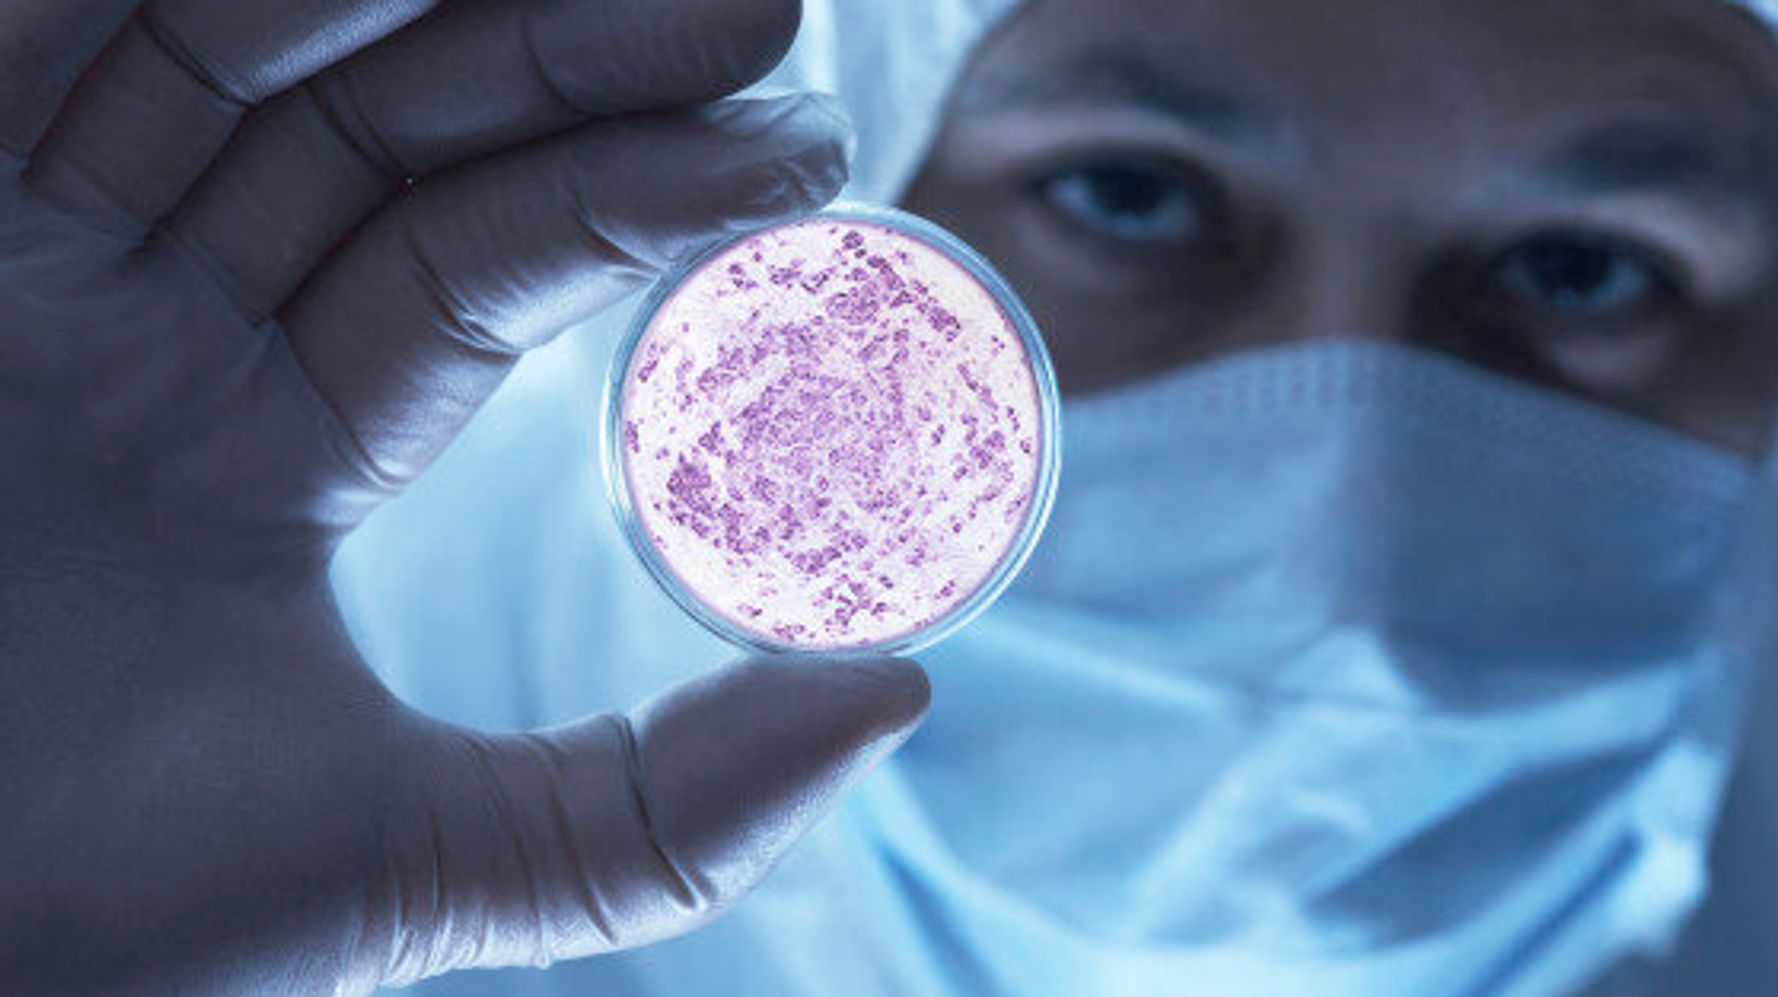
img

Granuloma annulare (GA) is skin disorder that most often causes a rash with red bumps (erythematous papules) arranged in a circle or ring pattern (annular).
The underlying cause of GA is unknown, but there are several factors that may trigger the disorder, including injury to the skin, viral infections, and certain medications and medical diseases.
[1][2][3][4][6] Some researchers propose unknown genetic factors may increase a person's risk to develop GA.[3][5] Diagnosis of GA is made by the appearance of skin lesions and lack of other physical findings or symptoms.
The color of the papules and plaques may be skin color, yellow, reddish pink, or violet.
Perforating GA presents with small bumps with crusted centers (umbilicated papules) that may leak fluid, itch, and be painful.
It has been reported to follow insect bites, sun exposure, tuberculin skin tests, tattoos, other injuries to the skin, certain medications (allopurinol, diclofenac, quinidine, calcitonin, amlodipine, ACE inhibitors, daclizumab, and calcium channel blockers), and viral infections (including Epstein-Barr, hepatitis C, herpes zoster, and HIV).